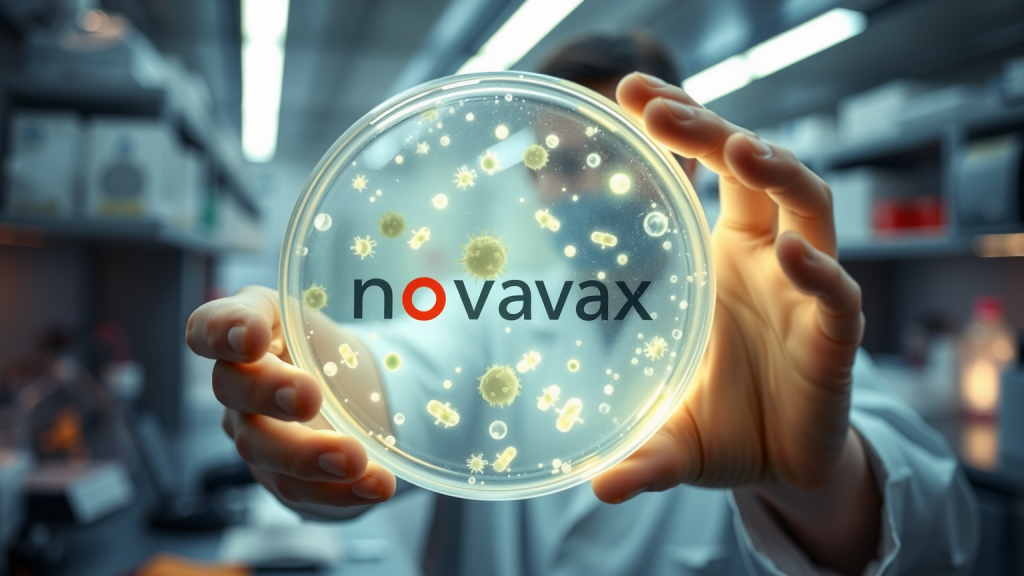
Forscher hält eine leuchtende Petrischale mit Novavax-Logo

Für Novavax steht 2026 ein fundamentaler Wandel an. Der Biotech-Konzern vollzieht den Übergang von einem direkten Impfstoffverkäufer zu einem Technologie- und Lizenzgeber. Diese strategische Neuausrichtung prägt die aktuelle Bewertung der Aktie, die am Freitag bei 7,27 US-Dollar schloss. Die Branchenkonferenz von J.P. Morgan Healthcare, die heute beginnt, dürfte weitere Hinweise auf den Erfolg dieses Kurswechsels liefern.
Singapur als Stützpfeiler
Ein zentrales Element für das internationale Geschäft bleibt die Verfügbarkeit des proteinbasierten Impfstoffs Nuvaxovid (JN.1) in Singapur. Das Land hat das Präparat in sein nationales Impfprogramm aufgenommen, das bis zum 31. Mai 2026 läuft. Dies sichert Novavax eine Präsenz im asiatisch-pazifischen Raum und unterstreicht die anhaltende Nachfrage nach einer Non-mRNA-Alternative.
Der Markt beobachtet nun, wie sich solche staatlich unterstützten Vertriebsabkommen in stetige Lizenzgebühren unter der erweiterten Partnerschaft mit Sanofi umwandeln. Die Aktie zeigt sich in den letzten zwei Wochen mit einem Plus von 4,76 Prozent relativ stabil, nachdem sie von einem Hoch bei 10,64 US-Dollar korrigiert hatte. Dies deutet auf eine vorläufige Konsolidierung in der Nähe der Unterstützung bei 7,11 US-Dollar hin.
Novavax, Inc. Aktie Chart
Neue Ertragsrealität
Finanzanalysten heben den Unterschied zwischen der früheren Hochumsatzphase und der aktuellen Übergangsperiode hervor. Während der bereinigte Gesamtumsatz für 2025 bei rund 1,05 Milliarden US-Dollar stabilisiert wurde, markiert die Prognose für 2026 den strategischen Wechsel. Das vorläufige Umsatzziel für das laufende Jahr liegt nur noch zwischen 185 und 205 Millionen US-Dollar.
Dieser deutliche Rückgang ist vor allem auf das Ende der direkten kommerziellen Verantwortung und die Abhängigkeit von Meilensteinzahlungen zurückzuführen. Rund 75 Millionen US-Dollar der Prognose hängen vom erfolgreichen Abschluss der Fertigungstechnologie-Übertragung an Sanofi ab. Die Aufmerksamkeit der Anleger verlagert sich daher von den Bruttoumsätzen hin zur geplanten Reduzierung der Betriebsausgaben, mit denen das Unternehmen bis 2028 die Profitabilität (non-GAAP) anstrebt.
Aktuelle Markt- und Finanzdaten:
* Letzter Kurs: 7,27 US-Dollar (Stand: 9. Januar 2026)
* 52-Wochen-Spanne: 5,01 – 10,64 US-Dollar
* Umsatzprognose 2026: 185 – 205 Mio. US-Dollar
* Umsatzrahmen 2025: 1,04 – 1,06 Mrd. US-Dollar
* Marktkapitalisierung: ca. 1,23 Mrd. US-Dollar
Volatilität bleibt bestimmend
Das technische Bild der Novavax-Aktie ist weiterhin von hoher Volatilität geprägt; im vergangenen Jahr gab es 47 Kursbewegungen von über 5 Prozent. Derzeit notiert die Aktie etwa 31 Prozent unter ihrem 52-Wochen-Hoch, was auf das Ausbleiben einer nachhaltigen Trendwende hindeutet. Das gestiegene Handelsvolumen bei fallenden Kursen in der letzten Sitzung könnte ein erstes Warnsignal für einen Test tieferer Unterstützungszonen sein.
Die Entkopplung vom breiteren Markt, etwa dem S&P 500, unterstreicht, dass unternehmensspezifische Nachrichten – wie klinische Daten zum Kombi-Impfstoff gegen COVID-19 und Influenza – der primäre Kurstreiber bleiben. Dementsprechend wird die Aktie im ersten Quartal voraussichtlich stark auf Neuigkeiten von der J.P. Morgan-Konferenz reagieren. Anleger erwarten konkrete Belege dafür, dass die neue Rolle als reiner Technologielieferant die Liquidität des Unternehmens ohne weitere Kapitalverwässerung sichern kann. Die nächsten Quartalszahlen am 26. Februar werden ein wichtiger Prüfstein sein.
Novavax-Aktie: Kaufen oder verkaufen?! Neue Novavax-Analyse vom 03. Juni liefert die Antwort:
Die neusten Novavax-Zahlen sprechen eine klare Sprache: Dringender Handlungsbedarf für Novavax-Aktionäre. Lohnt sich ein Einstieg oder sollten Sie lieber verkaufen? In der aktuellen Gratis-Analyse vom 03. Juni erfahren Sie was jetzt zu tun ist.